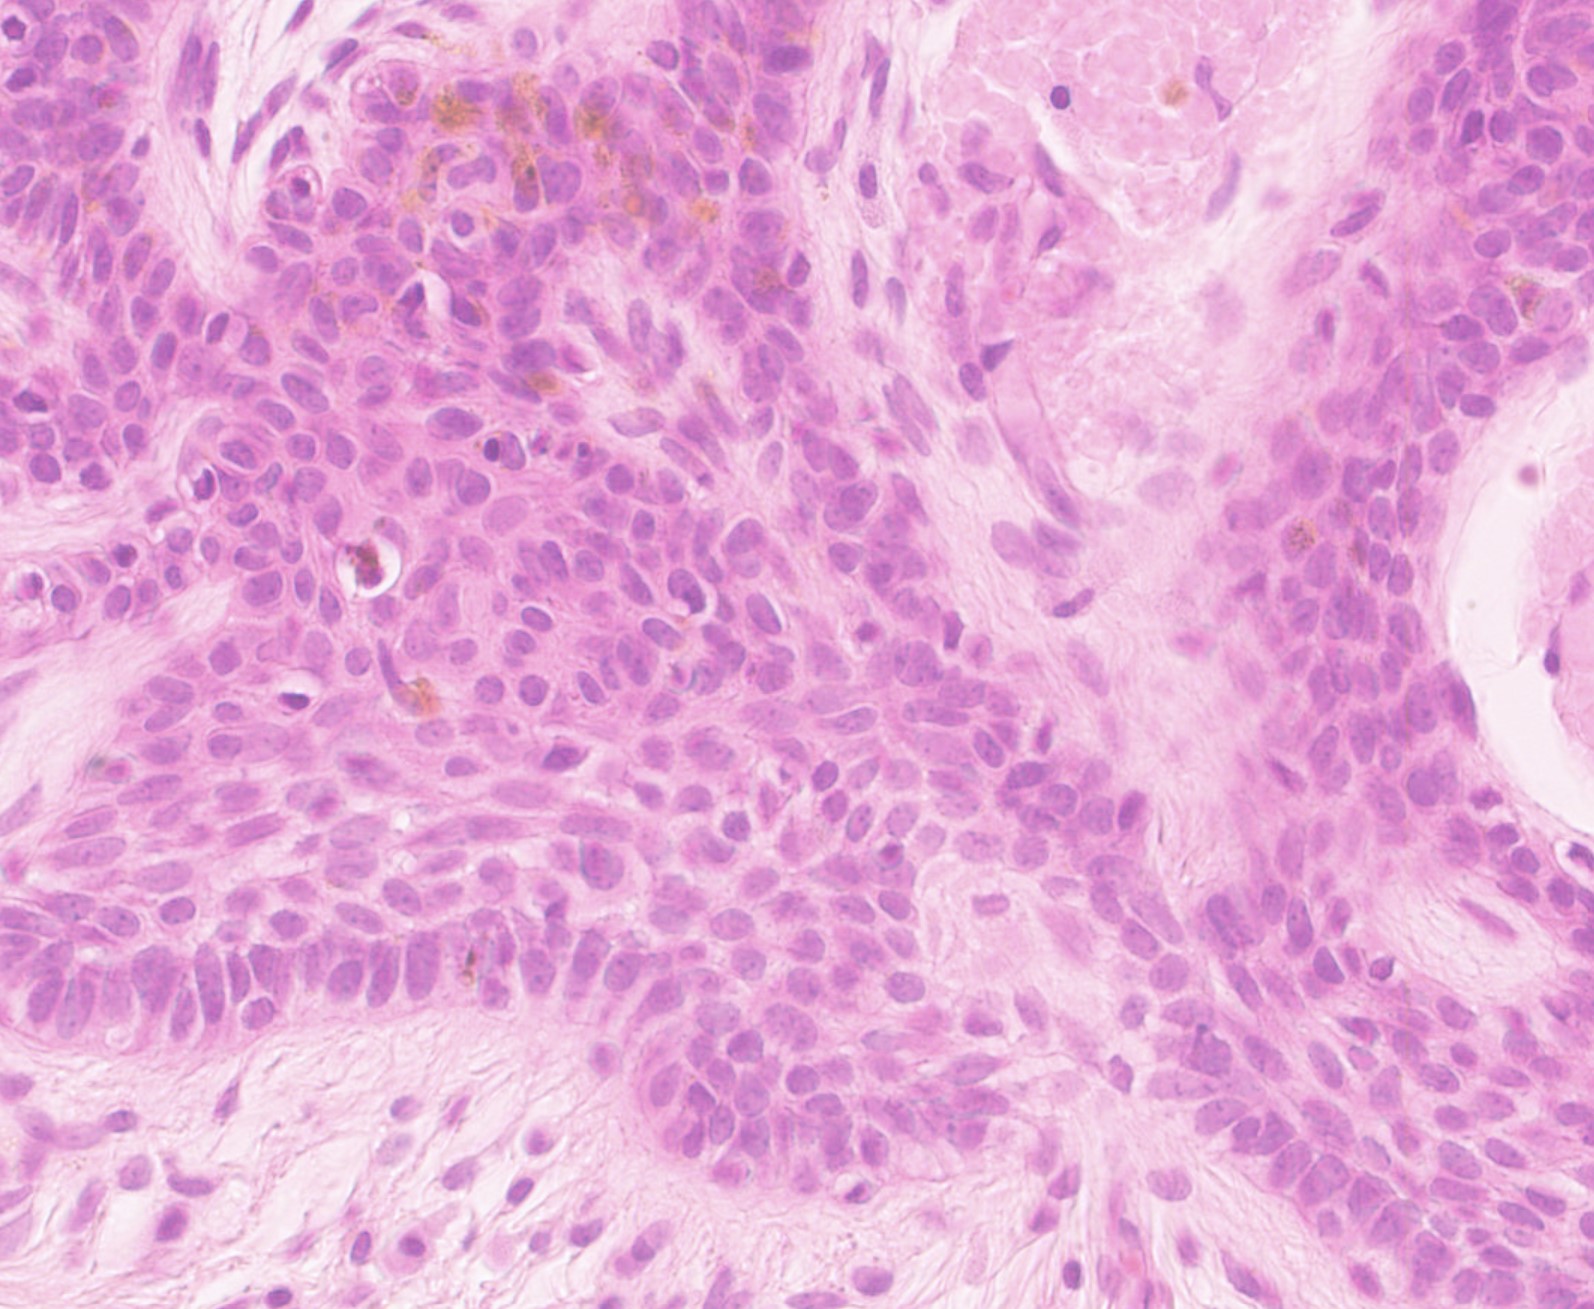
picture-3

Case Number : Case 4634 Posted By: Admin_Dermpath
Please read the clinical history and view the images by clicking on them before you proffer your diagnosis.
Submitted Date :
Male 70

Join the conversation
You can post now and register later. If you have an account, sign in now to post with your account.